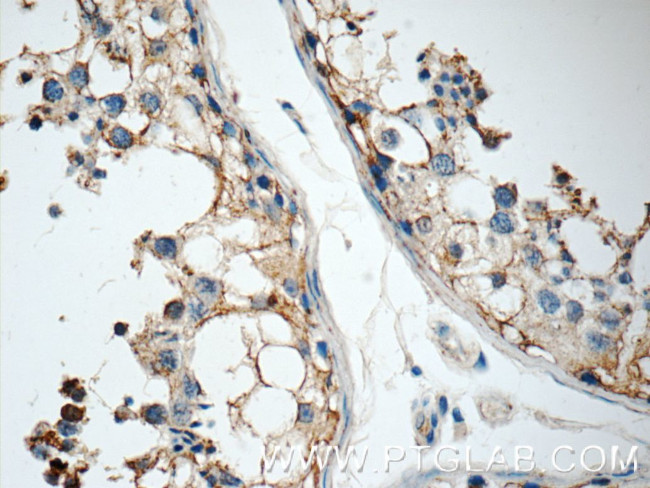
GSK3B Antibody in Immunohistochemistry (Paraffin) (IHC (P))

Search
Proteintech
GSK3B Polyclonal Antibody
{{$productOrderCtrl.translations['antibody.pdp.commerceCard.promotion.promotions']}}
{{$productOrderCtrl.translations['antibody.pdp.commerceCard.promotion.viewpromo']}}
{{$productOrderCtrl.translations['antibody.pdp.commerceCard.promotion.promocode']}}: {{promo.promoCode}} {{promo.promoTitle}} {{promo.promoDescription}}. {{$productOrderCtrl.translations['antibody.pdp.commerceCard.promotion.learnmore']}}
产品信息
15113-1-AP
已发表种属
宿主/亚型
分类
类型
抗原
偶联物
形式
浓度
规格
保存条件
运输条件
产品详细信息
This antibody recognize the 2 isoforms of GSK3B.
Immunogen sequence: MSGRPRTTS FAESCKPVQQ PSAFGSMKVS RDKDGSKVTT VVATPGQGPD RPQEVSYTDT KVIGNGSFGV VYQAKLCDSG ELVAIKKVLQ DKRFKNRELQ IMRKLDHCNI VRLRYFFYSS GEKKDEVYLN LVLDYVPETV YRVARHYSRA KQTLPVIYVK LYMYQLFRSL AYIHSFGICH RDIKPQNLLL DPDTAVLKLC DFGSAKQLVR GEPNVSYICS RYYRAPELIF GATDYTSSID VWSAGCVLAE LLLGQPIFPG DSGVDQLVEI IKVLGTPTRE QIREMNPNYT EFKFPQIKAH PWTKDSSGTG HFTSGVRVFR PRTPPEAIAL CSRLLEYTPT ARLTPLEACA HS (1-351 aa encoded by BC000251)
靶标信息
GSK3B is a proline-directed serine/threonine protein kinase involved in energy metabolism, neuronal cell development and body pattern formation. It is a negative regulator of glucose homeostasis and is involved in energy metabolism, inflammation, ER-stress, mitochondrial dysfunction, and apoptotic pathways. GSK3B is a critical component of the Wnt/beta-catenin signaling pathway, and its activity results in the inhibition of Wnt signaling by mediating the degradation of beta-catenin. GSK3B is also involved in the Hedgehog, Notch, and insulin signaling pathways.
仅用于科研。不用于诊断过程。未经明确授权不得转售。